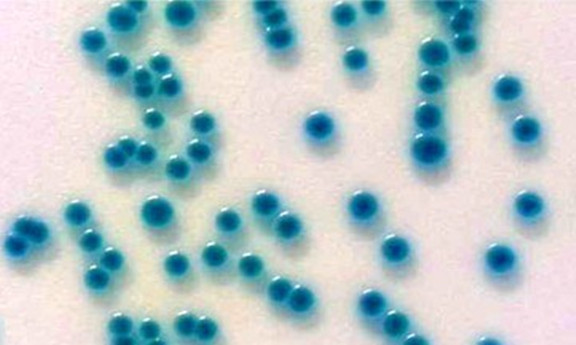
banqichangganjun.jpg

揪出奶粉的隐藏杀手--阪崎肠杆菌
发布日期:2018年08月22日 阅读量:2016年1月,国家食品药品监督管理局进行新一轮的婴幼儿配方乳粉国家专项监督抽检行动,涵盖89家在产企业产品,共计198批次,其中6批次不合格,2批次阪崎肠杆菌超标;
2016年5月,黑龙江食品药品监督管理局抽检瑞士有机婴幼儿乳粉品牌“泓乐”(Holle),发现阪崎肠杆菌超标,其奥地利生产厂家被中国认监委暂停了在华的注册资格,这是中国首次对海外乳品企业亮出“红牌”;
此前,贝因美、娃娃哈等乳业巨头产品也曾抽检出阪崎肠杆菌超标,消费者信任度一度骤降;
阪崎肠杆菌,一种条件性致病菌,属于肠道内正常菌群,革兰氏阴性菌,有鞭毛,无芽孢,耐干燥,在极干燥的环境中也能存在,如奶粉、茶叶、淀粉等。阪崎肠杆菌易感染人群是0~6月的新生儿,尤其早产儿、体重低下的婴儿和存在免疫缺陷婴儿。这是因为婴幼儿的胃酸比成人高,适合阪崎肠杆菌的生存,且婴幼儿的血脑屏障尚未发育完全,阪崎肠杆菌可进一步从血液进入脑部。极易引起脑膜炎、菌血症、坏死性小肠结炎,致死率高达40%~80%。
奶粉里的阪崎杆菌从何而来呢?原因可能是乳粉的原料携带病原或者生产环节中环境、器具、甚至操作人员存在着细菌。
那么,如何检测奶粉里的阪崎肠杆菌,保障产品品质和保护婴幼儿健康?
亚洲男人的天堂一区二区无码-亚洲熟伦熟女新五十路熟妇-小舞被催眠调教沦为肉奴视频网站-巨茎挺进李淑芬的体内视频-国产亚洲综合一区二区A片吴施蒙研发推出恒温荧光法检测阪崎肠杆菌的检测试剂盒,配合使用恒温荧光检测仪,经过样品前增菌、使用旋达R1细菌核酸提取试剂提取细菌核酸、核酸和试剂配制、置于恒温荧光检测仪中反应这四个步骤,反应时间30~45min,即可判读判读阴阳性结果。可适用于乳品生产企业对产品的快速检查;也适用于食品药品监督管理局、出入境检验检疫局等单位对大量乳粉样品的抽样检查,可作为快速检查和结果初筛的重要手段。





